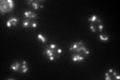

View description
Co-chaperone that stimulates the ATPase activity of the HSP70 protein Ssc1p; involved in protein folding/refolding in the mitochodrial matrix; required for proteolysis of misfolded proteins; member of the HSP40 (DnaJ) family of chaperones
Localization:
Intensity:
Fold change:
Significance:
-
C’ GFP library in SD

mitochondria60.8 -
N' NOP1pr-GFP in SD

mitochondria74.6221 -
N' TEF2pr-mCherry in SD

mitochondriaN/A -
N' NATIVEpr-GFP in SD

missing0 -
N' TEF2pr-VC and Cyto-VN in SD

#N/A0 -
C’ GFP library in SD+DTT

mitochondria63.21.03No -
C’ GFP library in SD+H2O2

mitochondria61.011No -
C’ GFP library in Starvation Media
mitochondria140.722.31Yes -
C’ GFP library on the background of Pup2-DaMP

mitochondria -
C’ GFP library on the background of CCT mutant

mitochondria46.30370.761436No
